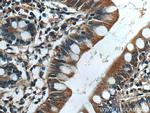
ASB13 Antibody in Immunohistochemistry (Paraffin) (IHC (P))
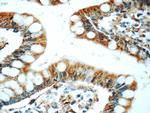
ASB13 Antibody in Immunohistochemistry (Paraffin) (IHC (P))
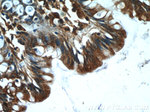
ASB13 Antibody in Immunohistochemistry (Paraffin) (IHC (P))
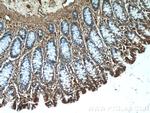
ASB13 Antibody in Immunohistochemistry (Paraffin) (IHC (P))

Search
Proteintech
ASB13 Polyclonal Antibody
{{$productOrderCtrl.translations['antibody.pdp.commerceCard.promotion.promotions']}}
{{$productOrderCtrl.translations['antibody.pdp.commerceCard.promotion.viewpromo']}}
{{$productOrderCtrl.translations['antibody.pdp.commerceCard.promotion.promocode']}}: {{promo.promoCode}} {{promo.promoTitle}} {{promo.promoDescription}}. {{$productOrderCtrl.translations['antibody.pdp.commerceCard.promotion.learnmore']}}
产品信息
25616-1-AP
种属反应
宿主/亚型
分类
类型
抗原
偶联物
形式
浓度
规格
纯化类型
保存液
内含物
保存条件
运输条件
产品详细信息
Immunogen sequence: AADGCFLGD VGFWVERTPV HEAAQRGESL QLQQLIESGA CVNQVTVDSI TPLHAASLQG QARCVQLLLA AGAQVDARNI DGSTPLCDAC ASGSIECVKL LLSYGAKVNP PLYTASPLHE ACMSGSSECV RLLIDVGANL EAHDCHFGTP LHVACAREHL DCVKVLLNAA (5-173 aa encoded by BC012056)
靶标信息
The protein encoded by this gene is a member of the ankyrin repeat and SOCS box-containing family of proteins. They contain ankyrin repeat sequence and a SOCS box domain. The SOCS box serves to couple suppressor of cytokine signalling proteins and their binding partners with the elongin B and C complex, possibly targeting them for degradation. Multiple alternatively spliced transcript variants have been described for this gene, but their full-length sequences are not known.
仅用于科研。不用于诊断过程。未经明确授权不得转售。
篇参考文献 (0)
生物信息学
蛋白别名: Ankyrin repeat and SOCS box protein 13; ankyrin repeat and SOCS box-containing protein 13; ankyrin repeat domain-containing SOCS box protein 13; ankyrin repeat domain-containing SOCS box protein Asb-13; ASB-13; ASB13; unnamed protein product
基因别名: 2210015B19Rik; 6430573K02Rik; Asb-13; ASB13; C85285
UniProt ID: (Human) Q8WXK3, (Mouse) Q8VBX0
Entrez Gene ID: (Human) 79754, (Mouse) 142688, (Rat) 361268